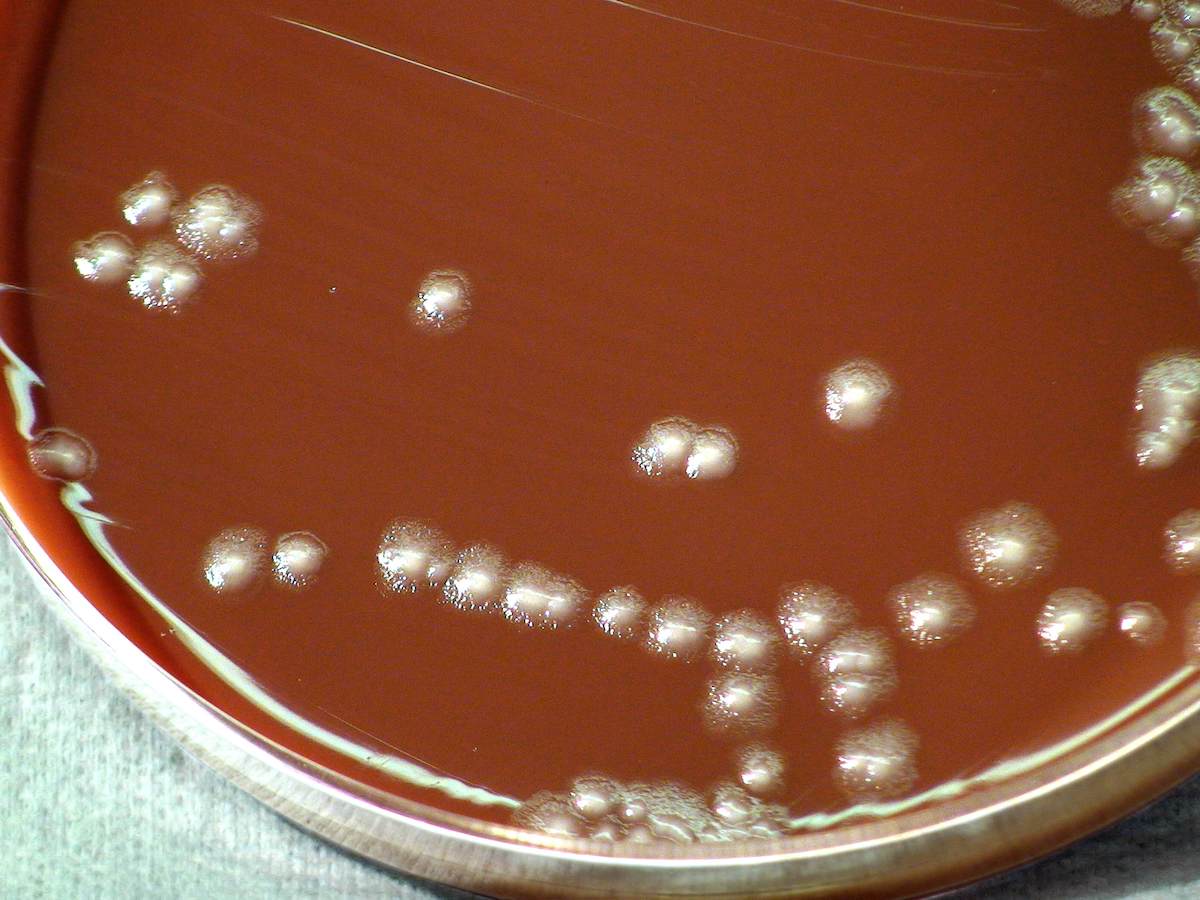

Es klingt dramatisch, aber derartige Fälle sind inzwischen Realität in deutschen Krankenhäusern und Patientenakten: “Ein Mann fällt in einen Bach, ertrinkt fast. Im Klinikum finden die Ärzte multiresistente Erreger in seiner Lunge. Kurz darauf stirbt der Mann. Die genaue Todesursache bleibt ungeklärt.”
Auch in der Hase unterhalb des Klärwerks in Eversburg könnte ein unfreiwilliges Bad zur Ursache einer tödlichen Infektion werden, wie Recherchen des NDR ergaben.
Mit der oben zitierten eindringlichen Schilderung eines aktuellen Falls aus Frankfurt, beginnt ein Textbeitrag, der auf der Homepage des NDR veröffentlicht wurde. Der Text erschien begleitend zu einer am Montagabend ausgestrahlten Radiosendung und im Vorfeld weiterer Ergebnisse, die am Dienstag zur Primetime in der ARD präsentiert werden sollen.
Antworten auf die Fragen unserer Leser zu den Ergebnissen der NDR-Recherche
Panorama-Reporter wurden in Osnabrück fündig
Der NDR hat in monatelanger Recherche eine Reise quer durch Niedersachsen gemacht. Journalisten der NDR Sendung Panorama – die Reporter wollten wissen, ob möglicherweise auch hier solche Keime in Gewässern zu finden sind. Die Reporter wurden unter anderem in Osnabrück fündig.
Neben der Radiosendung, die online bereits verfügbar ist, werden weitere Ergebnisse bei Panorama am Dienstagabend um 21:15 Uhr in der ARD gezeigt.

Kläranlage in Eversburg offensichtlich überfordert
Erste bereits veröffentlichte Ergebnisse zeigen für zwei Messstellen in Osnabrück dramatische Ergebnisse.
In der Hase, kurz hinter dem Auslauf des Klärwerks an der Klöcknerstraße in Eversburg, fanden die Wissenschaftler Erreger, gegen die bei einer Erkrankung fast kein Mittel mehr hilft – die also potentiell tödlich sein können.
Außerdem haben die Kollegen des NDR dort insgesamt sehr hohe Konzentrationen an multiresistenten Keimen gemessen. Beide Proben belegen ein generelles Problem: Kläranlagen in Deutschland sind derzeit nicht ausgerichtet, multiresistente Erreger komplett herauszufiltern.
Klinikum-Keime ungefiltert in die Hase?
Wo die Keine ihren Ursprung haben, bevor sie ungefiltert in den flussabwärts von Osnabrück idyllisch durch die Landschaft ziehenden Fluss gelangen, legen die weiteren Recheren auch nahe.
Es wurden in Osnabrück zusätzlich Proben direkt in der Kanalisation am Klinikum auf dem Finkenhügel genommen. Ausgerechnet dort, wo multireistente Keime eine permanente Gefahr für die Patienten sind, werden nach den online veröffentlichten Ergebnissen (hier als PDF im Download) genau die Keime in die städtische Kanalisation entlassen, die dann ungefiltert einige hundert Meter Luftlinie entfernt in Eversburg in die Hase entlassen werden.
Die direkt am Osnabrücker Klinikum und in der Hase nachgewiesenen Keime sind teils resistent gegen Antibiotika und können auch mit herkömmlichen Reinigungs- und Desinfektionsmitteln nicht unschädlich gemacht werden.

Hier wurden vom NDR in Osnabrück Proben entnommen:
[mappress mapid=”748″]